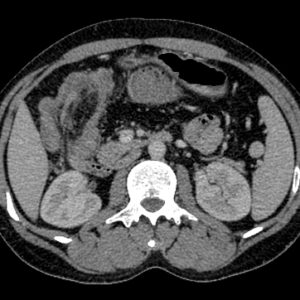
Lồng ruột

TIÊU HOÁ
Hiển thị 961–980 của 1445 kết quảĐã sắp xếp theo mới nhất
-

HCC
Lượt xem: 175» 25-04-2019 -

Chấn thương lách
Lượt xem: 160» 25-04-2019 -

Viêm túi mật
Lượt xem: 196» 19-04-2019 -

Thoát vị thành bụng
Lượt xem: 175» 17-04-2019 -

Thoát vị bẹn
Lượt xem: 315» 17-04-2019 -

U tụy
Lượt xem: 162» 16-04-2019 -

U cơ tuyến túi mật
Lượt xem: 155» 16-04-2019 -

HCC
Lượt xem: 212» 16-04-2019 -

Lồng ruột
Lượt xem: 255» 15-04-2019 -

Viêm đại tràng
Lượt xem: 203» 14-04-2019 -

Thủng tạng rỗng
Lượt xem: 1550» 08-04-2019 -

Viêm ruột thừa
Lượt xem: 238» 01-04-2019 -

U tụy
Lượt xem: 168» 28-03-2019 -

Di căn gan
Lượt xem: 143» 28-03-2019 -

Xơ gan
Lượt xem: 317» 27-03-2019 -

Tắc ruột
Lượt xem: 275» 22-03-2019 -

Polyp đại tràng
Lượt xem: 155» 22-03-2019 -

Polyp đại tràng
Lượt xem: 200» 22-03-2019 -

Polyp đại tràng
Lượt xem: 228» 22-03-2019 -

Viêm túi thừa đại tràng
Lượt xem: 361» 20-03-2019